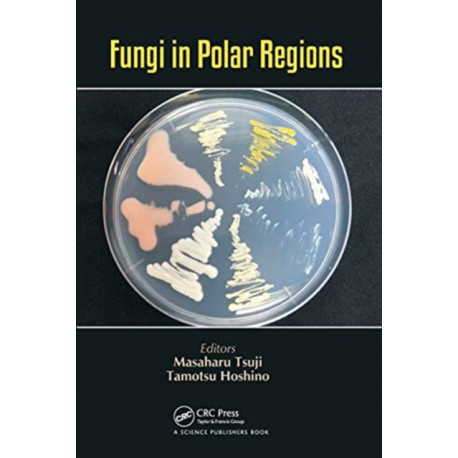
Fungi in Polar Regions

Kurv
Vare
varer
(tom)
Ingen varer
Fastlægges senere
Forsendelse
0,- kr
I alt
Fungi in Polar Regions
(Bog, Paperback / softback, Engelsk)
Forlag:
Taylor & Francis Ltd
- Type: Bog
- Format: Paperback / softback
-
Sprog:
Engelsk

- ISBN-13: 9780367779979
- Se flere detaljer ▼
Beskrivelse
Fungi that inhabit polar-regions can grow and decompose organic compounds under subzero temperatures and play an important role in the nutrient cycle of polar-region ecosystems. This book presents our current understanding of the mycoflora in polar-regions and their cold adaptation strategies, as well as potential applications.
Læsernes anmeldelser (0)
Alle detaljer
| Forlag | Taylor & Francis Ltd |
| Type | Bog |
| Format | Paperback / softback |
| Sprog | Engelsk |
| Udgivelsesdato | 31-03-2021 |
| Første udgivelsesår | 2021 |
| Fagredaktør | Masaharu Tsuji, Tamotsu Hoshino |
| Originalsprog | United Kingdom |
| Sideantal | 146 |
| Indbinding | Paperback / softback |
| Forlag | Taylor & Francis Ltd |
| Sideoplysninger | 146 pages |
| Mål | 234 x 156 |
| ISBN-13 / EAN-13 | 9780367779979 |

